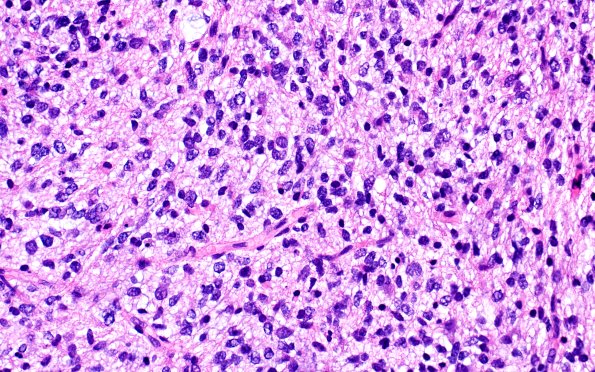
16B3 DMG (Case 16) H&E 40X 1

Table of Contents
Washington University Experience | NEOPLASMS (GLIAL) | Diffuse midline glioma, H3 K27-altered | 16B3 DMG (Case 16) H&E 40X 1
he cells have round to ovoid nuclei with mild atypia, fine chromatin, and micronucleoli in a subset. Mitoses are increased, and scattered karyorrhectic debris is present. Microvascular proliferation and necrosis are not appreciated in this limited sample. (H&E)